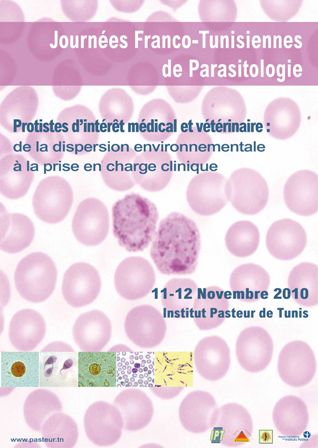

- Détails
- Affichages : 431
Du 20 au 24 mars 2012, un cours international en protéomique et conception de médicament se tiendra à l'Institut Pasteur de Tunis. Ce cours est organisé dans le cadre du projet européen Leishdrug financé par le Programme cadre 7.

- Détails
- Affichages : 636
Le 14 mars 2012 à 14h30, le laboratoire Venins et Biomolécules Thérapeutiques, de l'Institut Pasteur de Tunis organise une conférence,

- Détails
- Affichages : 389
Le Ministre de la Santé Publique, Abdellatif Mekki a reçu le 8 février 2012, une délégation tuniso-américaine composée du directeur général de l’Institut Pasteur de Tunis (IPT), Pr Hechmi Louzir,

- Détails
- Affichages : 514
Par Arrêté conjoint des Ministres de la Santé Publique et de la Recherche Scientifique, l'Institut Pasteur de Tunis (IPT) ouvre 5 postes de biologistes adjoints.
Ces biologistes adjoints seront recrutés pour les besoins des services et laboratoires suivants :

- Détails
- Affichages : 630
Le laboratoire de virologie clinique, dirigé par le Pr Henda Triki,

- Détails
- Affichages : 639
Dans le cadre de l'accord signé entre l'Institut Pasteur de Tunis, la JICA (Agence Japonaise de Coopération Internationale) et l'ATCT (Agence Tunisienne de Coopération Technique) pour la formation de participants africains dans les domaines d’expertise


- Détails
- Affichages : 368
Le 10 décembre 2011, à partir de 9h30, le comité national d'étique médical organise sa conférence annuelle sous le thème "Equité et accès à la Santé".
Cet événement a lieu à la Faculté de Médecine de Tunis et sous le Patronnage du ministre de la Santé Publique.

- Détails
- Affichages : 485
Du 1er au 3 décembre 2011, à l’hôtel Tej Marhaba à Sousse, l’Association Tunisienne d’Etude des Maladies Métaboliques Héréditaires (ATEMMH) organise deux manifestations pour réunir les acteurs concernés par ces

- Détails
- Affichages : 419
يتمنى لكم معهد باستور تونس رمضان مبارك و كل عام و انتم بخير

- Détails
- Affichages : 391
Du 13 au 19 novembre 2011 aura lieu à Tozeur le 3ème Cours International pour le Soutien Sanitaire en Milieu Saharien.


- Détails
- Affichages : 988
International des Instituts Pasteur a tenu, à Paris, sa réunion annuelle.
 La dernière journée a été consacrée aux jeunes chercheurs avec l’organisation du meeting international des jeunes chercheurs du RIIP.
La dernière journée a été consacrée aux jeunes chercheurs avec l’organisation du meeting international des jeunes chercheurs du RIIP.

- Détails
- Affichages : 1817
Les 31 octobre et 1er novembre 2011, l’American Association for Advancement in Science

- Détails
- Affichages : 353
Le 20 octobre 2011, à 9h30 dans l'amphithéâtre du batiment Recherche,


- Détails
- Affichages : 1092
Les lundi et mardi 12 et 13 septembre, à 15h00, dans le grand amphithéâtre de l'Institut Pasteur de Tunis,
deux conférences seront données respectivement par le Pr Manuel Carrondo et le Dr Paula M. Alves de l'Institut de biologie expérimentale et technologique (Portugal).

- Détails
- Affichages : 340
Les 12,13 et 14 mai 2011, la Société Tunisienne d’Immunologie organise ses

- Détails
- Affichages : 354
Le CNUDST (Centre National Universitaire de Documentation Scientifique et Technique),

- Détails
- Affichages : 387
Suite à la venue d'un très grand nombre de voyageurs venant se faire vacciner pour El Omra, l'Institut Pasteur de Tunis (IPT) souhaite apporter les renseignements suivants afin d'informer les citoyens tunisiens souhaitant se faire vacciner.

- Détails
- Affichages : 602
Les 10 et 11 mai 2011, l’Association Nationale des Médecins Vétérinaires de Tunisie (ANMVT)

- Détails
- Affichages : 1740
Les équipes de l'Institut Pasteur de Tunis vous présentent leurs meilleurs voeux pour l'année 2011

- Détails
- Affichages : 1293
Le laboratoire de virologie clinique, dirigé par le Pr Henda Triki,

- Détails
- Affichages : 496
Du 29 novembre au 18 décembre 2010, l'Institut Pasteur de Tunis

- Détails
- Affichages : 396
Du 13 au 18 décembre 2010, l’Institut Pasteur de Tunis organise un cours EMBO Global Exchange Lecture

- Détails
- Affichages : 374
Les 11 et 12 novembre 2010, l'Institut Pasteur de Tunis organise Les Journées Franco-Tunisiennes de

- Détails
- Affichages : 366
Du 1er au 5 novembre 2010, le laboratoire de contrôle des eaux et denrées alimentaires

- Détails
- Affichages : 479
L'Institut Pasteur de Tunis est fier d'annoncer la mise en ligne de

- Détails
- Affichages : 485
Le 8 octobre 2010, le Laboratoire de Recherche sur les Hépatites et les Maladies Virales Epidémiques,

- Détails
- Affichages : 771
Le 8 octobre 2010, à 9h30 l’Institut Pasteur de Tunis organise une matinée de conférences sur son Histoire, qui aura lieu dans le grand amphithéâtre

- Détails
- Affichages : 885
L’Institut Pasteur de Tunis a signé le 28 septembre 2010 un accord de coopération triangulaire avec la JICA

- Détails
- Affichages : 392
Du 20 au 22 septembre 2010 à l’hôtel Barcelo de Gammarth, l’Institut Pasteur de Tunis, avec le concours du Réseau


- Détails
- Affichages : 446
Le retrait des lots ID09/10 et ID11/10 du Vaccin BCG Lyophilisé Intradermique, du marché ont suscité des interrogations et parfois des inquiétudes chez certains de nos concitoyens.

- Détails
- Affichages : 1600
Du 17 au 19 juin 2010, l'Institut Pasteur de Tunis accueille la troisième Conférence Internationale de

- Détails
- Affichages : 739
Du 3 au 5 juin, les divisions arabe et britannique de l'académie internationale de pathologie organise

- Détails
- Affichages : 1082
Du 18 au 21 mai 2010, l'Ecole Doctorale des Sciences et Technologies du

- Détails
- Affichages : 692
Le vendredi 30 avril 2010, à la Cité des Sciences de Tunis l'Association Tunisienne

- Détails
- Affichages : 1140
Du 22 au 24 avril 2010, la Société Tunisienne de Pathologies Infectieuses




